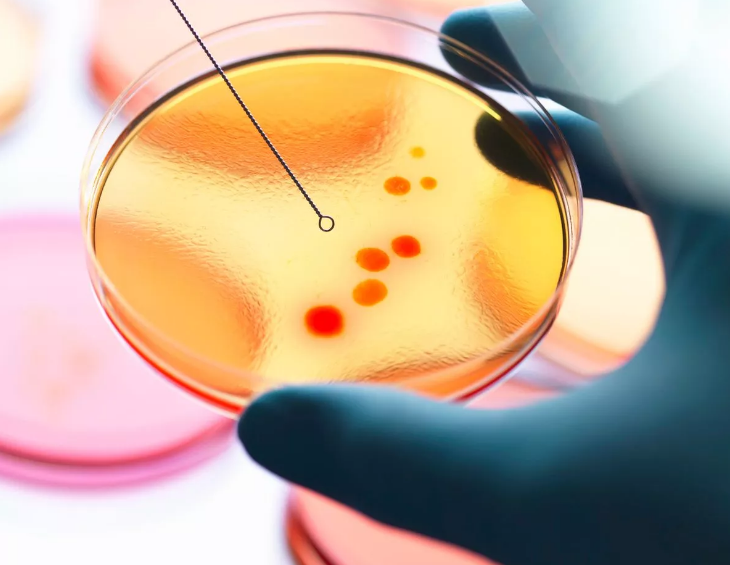
txt

بهاشتاج"حق نبيلة" و"إيقاف أوبر" ظهرت على مواقع التواصل الاجتماعي قصة اختطاف جديدة لسيدة مصرية على يد أحد سائقي أوبر، القصة التي تعيد إلى الأذهان قصة الشابة الراحلة "حبيبة الشماع" التي لقت نفس المصير ولكن كانت نهايتها الوفاة.
خلال الساعات القليلة الماضية أخذت قصة نبيلة الصدارة في المواضيع الأكثر تداولًا، وذلك بعد ما نشرت شقيقتها مدربة لياقة بدنية "سالي" عبر صفحاتها على السوشيال ميديا تفاصيل الحادث.
وكانت تفاصيل الحادث التي جاءت على لسان "سالي" عبر خاصية القصص على تطبيق "الانستجرام"، وقالت أنه يوم 11 مايو قمت بطلب رحلة أوبر من التجمع لزايد من هاتفي، وبعد دقائق أرسل السائق رقم أخر في خاصية الرسائل على تطبيق أوبر لنتمكن من التواصل معه ليتبين أنه رقمه الشخصي.
مع بداية الرحلة وجه السائق إلى السيدة نبيلة سؤال وهو "الرحلة كاش ولا فيزا؟" أجابته بأنها فيزا، ليطلب منها أن تلغي الرحلة وتتم محاسبته كاش، وعندما أبلغته أن الرحلة تمت من خلال التطبيق على هاتف شقيقتها أصر على أن تقوم بالاتصال بـ "سالي" وإلغاء الرحلة.
بالفعل قامت "نبيلة" بالاتصال بسالي وطلبت منها إلغاء الرحلة ولكنها رفضت ذلك لكي تطمئن عليها وزيادة في الأمان، فقام السائق بإلغاء الرحلة من طرفه، بعد ما توقف في منطقة خالية بالتجمع الثالث.
فوجئت "سالي" بعد قليل باتصال 3 كباتن مختلفين يدعون أنهم من أوبر، ويعرضون عليها توصليها إلى شقيقته "نبيلة" لتزيد تلك المكالمات القلق والرعب لدى "سالي" حول مصير شقيقتها.
في نفس الوقت كانت "نبيلة" في قلب الخطر، حيث أوقف السائق السيارة في المنطقة الهادئة وأدعى نزولها من السيارة لشرب المياه من شنطة السيارة، حينذاك أخرج مطواة من شنطة السيارة وفتح باب العربية ليهاجم "نبيلة" بقوة وهو يردد "شايفة دي ؟ همو.تك بيها".
قاومت "نبيلة" اعتداء السائق الوحشي وأمسكت المطواة بأيديها حتى نزفت الكثير من الدماء، بينما ظل يلكمها ويضرب بقوة على وجهها ورأسها،وهو يحاول الاعتداء عليها جسديا ولكنها ظلت تقاومه وهي تردد "مش هتلمسني غير لو موتني"، حتى تمكنت أخيرًا من الهرب.
لم تمر ساعات قليلة على الحادث حتى تمكنت المباحث من القبض على السائق ومعاونيه، ووجهت سالي الشكر إلى قوات الشرطة، وأكدت على إنها وشقيقتها سيظلوا وراء السائقين للحصول على حقهم بالكامل، كما وجهت إتهامات لـ "اوبر "لإهمالهم وأعلنت عن نيتها في محاسبة الشركة.
أصبحت محاسبة شركة "أوبر" مطلب من قبل الكثيرين على مواقع التواصل الاجتماعي، وهناك من طلب بإيقاف عمل الشركة في مصر، بينما آخرون يجدون أن المشكلة ليست في الشركة بينما في الأشخاص أنفسهم.